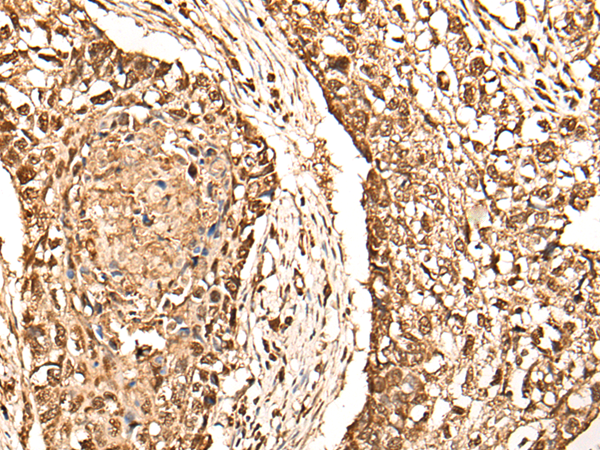

别名:Rb2; P130应用:WB,IHC
反应种属:Human, Mouse, Rat
规格:50μl/100μl
| Description |
|---|
| Retinoblastoma-like protein 2 is a protein that in humans is encoded by the RBL2 gene. Key regulator of entry into cell division. Directly involved in heterochromatin formation by maintaining overall chromatin structure and, in particular, that of constitutive heterochromatin by stabilizing histone methylation. Recruits and targets histone methyltransferases SUV420H1 and SUV420H2, leading to epigenetic transcriptional repression. Controls histone H4 ‘Lys-20’ trimethylation. |
| Specification | |
|---|---|
| Aliases | Rb2; P130 |
| Swissprot | Q08999 |
| WB Predicted band size | 128 kDa |
| Host/Isotype | Rabbit IgG |
| Storage | Store at 4°C short term. Aliquot and store at -20°C long term. Avoid freeze/thaw cycles. |
| Species Reactivity | Human, Mouse, Rat |
| Immunogen | Synthetic peptide of human RBL2 |
| Formulation | pH7.4 PBS, 0.05% NaN3, 40% Glycerol |
| Application | |
|---|---|
| WB | 1/200-1/1000 |
| IHC | 1/30-1/150 |
| ELISA | 1/5000-1/10000 |
![]() |
Gel: 6%SDS-PAGE, Lysate: 40 μg, Lane: Lncap cell, Primary antibody: P04620(RBL2 Antibody) at dilution 1/200, Secondary antibody: Goat anti rabbit IgG at 1/8000 dilution, Exposure time: 4 minutes |
![]() |
The image is immunohistochemistry of paraffin-embedded Human lung cancer tissue using P04620(RBL2 Antibody) at dilution 1/40. (Original magnification: ×200) |
![]() |
The image is immunohistochemistry of paraffin-embedded Human brain tissue using P04620(RBL2 Antibody) at dilution 1/40. (Original magnification: ×200) |
本公司的所有产品仅用于科学研究或者工业应用等非医疗目的,不可用于人类或动物的临床诊断或治疗,非药用,非食用。
暂无评论
本公司的所有产品仅用于科学研究或者工业应用等非医疗目的,不可用于人类或动物的临床诊断或治疗,非药用,非食用。
中文

发表回复